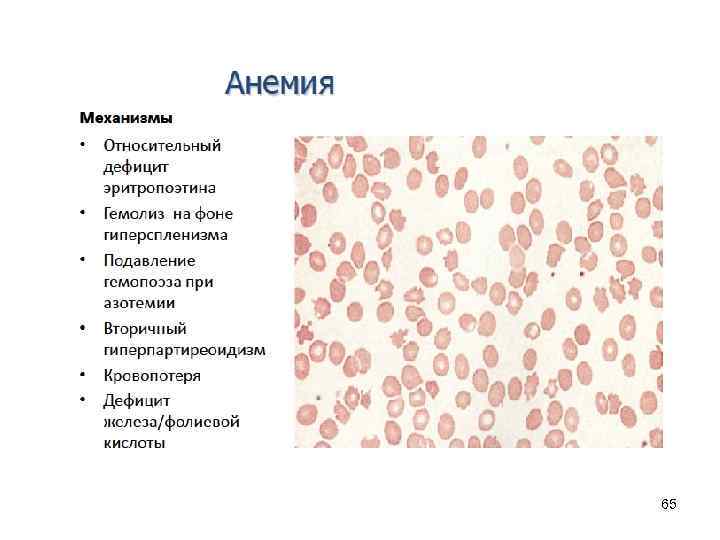
65

Лекция СтФ почки 20.04.2013.ppt
- Количество слайдов: 66

Стоматологический факультет ПАТОФИЗИОЛОГИЯ ПОЧЕК 2012/2013 учебный год 1

ОСНОВНЫЕ ФУНКЦИИ ПОЧЕК I. Экскреторная : • Выделение метаболитов, в основном, продуктов азотистого обмена. Накопление азотистых шлаков приводит к уремии. • Выделение поступивших в организм чужеродных веществ, ядов, водорастворимых лекарственных веществ. • Регуляция водно-электролитного баланса, осмолярности внеклеточной жидкости. Задержка воды, солей, что может привести к отёку, гиперкалиемии. • Поддержании кислотно-основного состояния (КОС) крови и других сред организма. При нарушении этой функции развивается метаболический ацидоз. • Почки осуществляют реабсорбцию воды, поддерживают на определённом уровне ОЦК. 2

II. Инкреторная : Участие в регуляции кровяного давления. При ишемии почек, возникает артериальная гипертензия. Участие в регуляции эритропоэза. В почках вырабатывается эритропоэтин, недостаток которого приводит к анемии. В почках вырабатываются биологические активные вещества (БАВ): простагландины, урокиназа. 3

4

5

6

7

Давление в сосудах и канальцах нефрона 8

Скорость клубочковой фильтрации 1. Фильтрационное давление 2. Проницаемость фильтра 3. Площадь фильтрационного поля 9

10

Фильтрационное давление Давление в капиллярах клубочков Онкотическое давление плазмы крови + 55 -60 30 Давление в капсуле 10 -20 15 -20 Суммарное (эффективное) фильтрационное давление 11

Функции нефрона Реабсорбция Фильтрация Vдиурез= Vфильтрация -Vреабсорбция секреция 12

Реабсорбция и секреция в нефроне 13

Канальцы почек: ацидогенез: 1 - бикарбонатная буферная система: H++HOˉ H 2 O+CO 2 Н 2 СО 3 НСО 3ˉ + Н++Na+ Na. НСО 3+ Н+ 2 -фосфатная буферная система H++Na 2 HPO 4ˉ Na+ + Na. H 2 PO 4ˉ Эти механизмы выделения Н+ действуют пока р. Н мочи не ниже 4, 5. p. H< 4, 5 может привести к повреждению почечного эпителия. Поэтому включается 3 -й механизм аммониогенез: реакция окислительного дезаминирования глутамина. Аммиак соединяется с ионами Н+, превращается в ион аммония NH 4+ Глутаминаза Глутаминовая кислота NH 3+Н+ 14

15

Ишемическое повреждение эпителия канальцев 16

ПРИЧИНЫ И МЕХАНИЗМЫ НАРУШЕНИЯ РЕАБСОРБЦИИ • I-я группа причин - нарушения функции канальцевого эпителия - связана с действием патогенных факторов на структурные элементы и биохимические процессы, протекающие в канальцевом эпителии. • 1. Структурные изменения канальцев при интоксикации (отравлении препаратами ртути сулемовая почка). • 2. Воспалительные поражения канальцев нефроз. • При нефрозе происходит отторжение, слущивание эпителия канальцев. Нарушаются не только процессы диффузии и осмоса, но и другие механизмы реабсорбции, , если фильтрация нарушена - возникает анурия (ОПН). 17

• II группа нарушений связана с функцией механизмов активного транспорта канальцевого эпителия. • 1. Повышенное содержание в первичной моче веществ, превышающих возможности их активного транспорта ферментными системами канальцев. • Cахарный диабет сопровождается гипергликемией. • В норме в крови содержится 3, 3 -5, 5 ммоль/л глюкозы. • Глюкоза в крови попадает в первичную мочу и полностью из неё реабсорбируется в канальцах (в моче обычно глюкозы нет). Гипергилкемия в 6, 2 м. М/л не сопровождается глюкозурией, так как такое количество глюкозы реабсорбируется. • Уровень сахара в крови 10 м. М/л является почечным порогом. При повышении почечного порога ферментные системы канальцев не в состоянии реабсорбировать всю глюкозу из провизорной мочи, возникает глюкозурия. • При сахарном диабете нарушается не только углеводный, но и другие виды обмена веществ, в частности - жировой. • В результате нарушения жирового обмена в крови и моче появляются кетоновые тела, возникает кетонемия и кетонурия. • Аналогичный механизм реабсорбции аминокислот. Гипераминоацидемия приводит к аминоацидурии. 18

2 - блокада ферментных систем, ответственных за транспорт глюкозы • Пример - токсическое действие на ферментные системы канальцев флоридзина. • При введении животным флоридзина, развивается флоридзиновый или почечный диабет (экспериментальная модель глюкозурии) - при нормальном и даже низком содержании глюкозы в крови возникает глюкозурия. • Фармакологическая блокада ферментных систем реабсорбции возникает при назначении мочегонных препаратов (ртутных диуретиков, урегида) блокируется механизм реабсорбции натрия 19

3 - генетические дефекты ферментных систем реабсорбции • Происходит нарушение реабсорбции отдельных веществ ( цистина, фруктозы). • В клинике встречается синдром Фанкони: - генетический дефект реабсорбции аминокислот, глюкозы, фосфатов - сопровождается аминоацидурией, глюкозурией, фосфатурией. 20

21

3 -я группа изменений функций канальцев - нарушения микропиноцитоза • В норме в моче белок (не более 0, 01%) - не определяется. • Канальцевый эпителий активно захватывает белки низкого молекулярного веса. • В эпителиальной клетке происходит взаимодействие белка с лизосомами, образуется фагосома, в которой происходит гидролитическое расщепление белков до аминокислот и реутилизация белков из первичной мочи. • Нарушения пиноцитоза могут возникать при гипоксии, расстройствах почечного кровотока, трофических изменениях канальцевого эпителия. • Эти изменения сопровождаются появлением белка в моче - протеинурией. Потери белка с мочой могут при патологии доходить до 50 г/сутки. 22

Нарушение механизма реабсорбции натрия • Реабсорбция Na+ происходит против электрохимического градиента, против градиента концентрации ионов. • В интерстициальной ткани ионов Na+ больше, чем в просвете канальцев. • Реабсорбция осуществляется с помощью натриевого насоса и сопровождается затратами энергии. В реакции принимает участие К/Na-зависимая АТФ-аза. • Реакция чувствительна к кислородному голоданию и нарушается при гипоксии. 23

24

Нарушения реабсорбции в канальцах могут обусловлены внепочечными причинами (изменением нейро-эндокринной регуляции) • Изменение выработки ваозпрессина (АДГ): • Недостаток выработки вазопрессина приводит к развитию несахарного диабета, при котором уменьшается реабсорбция воды в дистальных отделах канальцев и собирательных трубочках. • Диурез увеличивается до 10 -12 л в сутки, появляется мучительная жажда. • При избыточной продукции вазопрессина (синдром Пархона) возникает задержка воды - гипергидратация организма. 25

• Увеличение в моче осмотически активных веществ, назначаемых с лечебной целью приводит к изменению реабсорбции воды. • При повышении в моче глюкозы, мочевины возрастает осмотическийдиурез. • Осмотически активным веществом является манитол, используемый в клинике. 26

Механизмы нарушения реабсорбции воды • Увеличение объема фильтрата) (гиперволемия) • Гиперосмолярность мочи (глюкоза, мочевина и т. д. ) • Нарушение реабсорбции Na, глюкозы и т. д. ) • Нарушение регуляции реабсорбции воды (несахарный диабет) 27

Причины несахарного диабета Центрального генеза Почечного генеза Наследственный Аутосомно-доминантный Аутосомно-рецессивный Приобретенный Травмы Опухоли Инфекция Сцепленный с Х-хромосомой Аутосомно-рецессивный Приобретенный Заболевания почек Гиперкальциемия Гипокалиемия 28

29

30

ПРОТЕИНУРИЯ Протеинурия – повышенное содержание белка в моче. Нормой является выделение в мочу около 150 (в некоторых случаях до 300) мг белка в сутки. Большее количество белка свидетельствует о нарушении проницаемости гломерулярной мембран клубочков. ПРИЧИНЫ ПРОТЕИНУРИИ: • заболевания почек (острый и хронический гломерулонефрит, нефропатия беременных, пиелонефрит и др. ); • заболевания мочевыводящих путей (воспаление мочевого пузыря, предстательной железы, мочеточников). 31

Механизмы протеинурии • Потеря заряда фильтрационного барьера • Повышение порозности фильтрационного барьера • Гиперпротеинемия • Нарушение реабсорбции белка 32

33

34

35

36

ВИДЫ ПРОТЕИНУРИИ: • Протеинурия застойная– вызывается застоем крови в почках при сердечной недостаточности; • Протеинурия истинная (почечная) – вызывается нарушением фильтрационной способности почек; • Протеинурия «ложная» (внепочечная)- вызывается попаданием белка в мочу при ее прохождении по мочевым путям, пораженным воспалительным или деструктивным процессом; • Протеинурия лордотическая (ортостатическая) – вызывается поясничным лордозом, вызывающим венозный застой в почках. • Протеинурия пальпаторная – появляется после бимануальной пальпации почки; • Протеинурия пароксизмальная – кратковременное проявление протеинурии, появляющееся после гипертонического или вегетативного криза, эпилептического припадка; • Протеинурия спортсменов – появляется после большой физической нагрузки; • Протеинурия транзиторная (функциональная) – появляется на короткое время после мышечного напряжения или переедания. Такие виды протеинурии, как пароксизмальная, транзиторная являются кратковременными и не требуют лечения. 37

38

39

40

41

42

43

44

45

46

Ричард Брайт (1789 -1858) отмечал, что для поражения почек характерно появление одного из 3 -х синдромов: 1. почечного, 2. гипертонического, 3. отёчного, или их сочетания 47

Почечная недостаточность – • патологическое состояние, при котором почки неспособны достаточно интенсивно выделять азотистые метаболиты, обеспечивать водноэлектролитный баланс и кислотно-основное равновесие организма. 48

Причины ОПН 1. • • Преренальная ОПН Артериальная гипотензия Сердечная недостаточность Гиповолемия Чрезмерная констрикция почечных сосудов 49

Основные причины постренальной почечной недостаточности 50

• • В течении ОПН выделяют 4 периода: начальный, олигоурии или анурии, восстановления диуреза (сопровождается полиурией), • исход (выздоровление и пр. ). • I пероид - изменения в организме и клиническая картина начального периода определяются действием этиологического фактора: шок, острый гемолиз, мочекаменная болезнь и т. д. 51

• • II-ой период олигурии длится от 2 -х суток до 2 -х недель и характеризуется резким уменьшением фильтрации и диуреза: менее 50 мл (анурия), или 50 -500 мл (олигоурия). В этой стадии характерны следующие изменения: Гипергидратация - задержка воды (в норме в организме образуется до 300 мл эндогенной воды). Накопление воды (отёки) приводит к уменьшению концентрации натрия – гипонатриемии, возникает гипоосмолярная гипергидратация. • • • Гиперкалиемия вследствие недостаточного выведения калия, усиленного распада клеток и выхода внутриклеточного калия. Последствия: нарушения сердечной деятельности. • • • Гипермагниемия: механизм - недостаточное выведение и распад клеток и тканей. Последствия - депрессия ЦНС. • Происходит задержка фосфатов и сульфатов - возникает ацидоз. Гиперфосфатемия в сочетании с гипокальциемией приводит к усилению функции паращитовидных желёз, изменяется Р- и Саобмен. 52

53

• III период полиурии - восстановления диуреза, длится в среднем 20 дней. • Иногда развивается бурно. Количество мочи достигает нескольких литров. Вода уходит из организма, возникает дегидратация. • Отмечаются жажда, сухость кожных покровов, потеря веса. • С мочой теряются ионы К+, возникает гипокалиемия. У больных появляются жалобы на боли в сердце, экстрасистолия, изменения на ЭКГ. • Полиурия имеет компенсаторный характер, направлена на снижение азотемии, уменьшение содержания креатинина, мочевины в крови, нормализацию её электролитного баланса. 54

IV-й период выздоровления • Начинается с момента нормализации содержания в крови мочевины и креатинина. • Продолжается от 6 месяцев до 2 -х лет. • В течение этого периода восстанавливаются клубочковая фильтрация, почечный кровоток, концентрационная способность почек. 55

56

Нарушения при ХБП • • • Интоксикация Нарушения ЦНС, сердечно-сосудистой, Нарушения ВЭБ, КОС дыхательной систем, Гипопротеинемия ЖКТ Гиперлипидемия Остеопороз Анемия Нарушение свертываемости крови Иммуносуппрессия Эндокринные нарушения 57

Факторы уремической интоксикации • • • • • «Молекулы средней массы» Ацетон Метилгуанидин Алифатические амины Аминокислоты 2, 3 -бутиленгликоль Оксалаты Диаминоксидаза Фенолы, Полиамины Производные пиридина, Гуанидинсукцинат Индолы Креатинин Мочевина Мочевая кислота Гормоны и БАВ (ПТГ, ренин, гастрин, глюкагон, СТГ и др. ) + недостаточное образование эритропоэтина, гидроксилирования витамина Д и т. д. 58

Вследствие нарастания гиперазотемии и интоксикации нарушения обмена веществ, функции органов и систем возникает ряд синдромов: • • • астенический синдром (апатия, вялость, депрессия); диспептический синдром (выделение азотистых шлаков через слизистые ЖКТ) - потеря аппетита, тошнота, диспепсические расстройства); анемический синдром (нарушение образования эритропоэтина); серозно-суставной и костный синдром (нарушение обмена мочевой кислоты) - боли в суставах, выпот в серозные полости; гипертонический синдром (нарушение почечного кровотока); мочевой синдром (вследствие нарушения функции клубочков и канальцев - появление патологических составных частей мочи). При падении клубочковой фильтрации ниже 10 мл/мин наступает терминальная (уремическая) стадия, развивается олигурия. Нарастают азотемия, ацидоз, гипергидратация. Возникают гипонатриемия, гипохлоремия, (разбавление ионов вследствие гипергидратации), гипермагниемия, гиперкалиемия. 59

60

61

Механизмы вторичного гиперпаратиреоидизма при почечной недостаточности 1. Гиперфосфатемия и отрицательный кальциевый баланс 2. Недостаточное образование 1, 25 -дигидровитамина Д 3 3. Снижение плотности кальциевых рецепторов на паращитовидных железах 4. Увеличение концентрации цитокинов 5. Резистентность к ПТГ 6. Замедление клиренса ПТГ 62

63

64
65

66
Лекция СтФ почки 20.04.2013.ppt